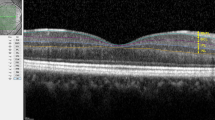

Abstract
Objective
To examine structural changes in retinal layers over time in patients with non-arteritic anterior ischaemic optic neuropathy (NAION) and determine the layers that predict visual outcomes.
Methods
The optical coherence tomography parameters in NAION eyes at <2 months, 2–5 months, and 6–18 months from the onset were compared to age-matched normal controls. Generalised estimating equation analysis was used to analyse the changes over time and regression analysis was performed to identify the layer that could predict visual field outcomes.
Results
Less than 2 months from the onset, the peripapillary retinal nerve fibre layer (RNFL) (p = 0.001) and macular outer nuclear layer (ONL) (p = 0.024) were significantly thicker in the NAION eyes than in the control eyes. The average peripapillary RNFL, macular RNFL, and ganglion cell layer and inner plexiform layer (GCIPL) showed reductions in thickness within 2–5 months (peripapillary RNFL: −19.8 μm/month, p < 0.001, macular RNFL: −14.5 μm/month, p < 0.001, GCIPL: −26.8 μm/month, p < 0.001). The change of thickness in temporal and superior peripapillary RNFL, GCIPL, inner nuclear layer (INL), and ONL by 2–5 months was associated with the final visual field results (p = 0.018, p < 0.001, p = 0.040, p = 0.020, and p = 0.002, respectively).
Conclusions
The peripapillary RNFL swelling initially observed started to decrease within 2–5 months along with macular RNFL and GCIPL thinning. The rate of thickness changes in the peripapillary RNFL, GCIPL, INL, and ONL by 2–5 months was associated with visual field outcomes.
Similar content being viewed by others
Introduction
Non-arteritic anterior ischaemic optic neuropathy (NAION) is one of the most common acute optic neuropathies in people over the age of 50 [1]. It is an acute or subacute optic neuropathy resulting from small vessel infarction of the anterior optic nerve, which is supplied by the posterior ciliary artery circulation [2]. NAION leads to retinal ganglion cell loss and optic nerve atrophy after the acute episode [3]. Past studies using optical coherence tomography (OCT) revealed peripapillary retinal nerve fibre layer (RNFL) thinning [4, 5] and macular ganglion cell loss [4, 6] in the chronic phase of NAION. In the acute phase, the RNFL is reported to be thickened in association with optic disc swelling [7].
The recent development of high-resolution spectral-domain (SD)-OCT permitted analysis of individual retinal layer thicknesses, including the RNFL and the ganglion cell layer (GCL) [8]. One study on the early phase of NAION reported outer nuclear layer (ONL) thickening at the baseline and macular RNFL and GCL thinning after 1 month [9]. The authors reported that these changes were well-correlated with visual function in patients with NAION [9]. A cross-sectional study on both acute NAION and chronic NAION reported peripapillary RNFL, GCL/inner plexiform layer (IPL), ONL, and photoreceptor layer (PRL) thickening in patients with acute NAION and peripapillary RNFL and macular GCL/IPL thinning in patients with chronic NAION [10].
In the present study, we aimed to investigate what additional information could be derived by longitudinal retinal layer segmentation analyses through 1 year after an acute episode of NAION using SD-OCT.
Methods
Patients
We retrospectively studied eyes with new-onset NAION diagnosed in the Neuro-ophthalmology Department of the Samsung Medical Center between November 2013 and July 2019. NAION patients with symptom onset (defined as the onset of visual loss consistent with NAION) 30 days or more from the baseline assessment were not included in this study. This research was approved by the Samsung Medical Center Institutional Review Board and adhered to the tenets of the Declaration of Helsinki. Informed consent was waived for the patients with NAION. Written informed consent was obtained from the healthy controls prior to the ophthalmic examinations.
The inclusion criteria included (1) the development of painless vision loss within 30 days of documented optic disc swelling confirmed by an ophthalmologist; (2) patient age between 40 and 85 years; (3) visual field loss typical of NAION (not just an enlarged blind spot); (4) a relative afferent pupillary defect, unless the fellow eye was affected in the past or both eyes were simultaneously affected with similar intensity; and (5) a maximum spherical ametropia of ±6 dioptres and maximum cylindrical ametropia of ±3 dioptres.
The exclusion criteria included (1) history or signs of any other intraocular, orbital, or intracranial disease; (2) history of ocular trauma; (3) other types of optic neuropathy suggested by history or blood tests (complete blood count, C-reactive protein, erythrocyte sedimentation rate, rapid plasma regain, lupus anticoagulant, Toxocara canis IgG Ab, toxoplasma IgG and IgM Abs, Lyme disease serology, Bartonella Ab, Q fever Ab, AQP4 Ab, paraneoplastic Ab (anti-Hu, anti-Ri, anti-Yo, anti-amphiphysin, anti-CV2/CRMP5, and anti-PNMA2 (Ma2/Ta), anti-recoverin, anti-SOX1, and anti-titin (MGT-30)); (4) medication known to affect visual function (e.g. ethambutol, digoxin and vigabatrin) or to cause miosis (e.g. opioids); and (5) follow-up <6 months.
As controls, we also recruited 21 age-matched disease-free subjects from the staff and healthy volunteers, none of whom had a history of ocular or neurologic disease and proceeded with informed consent for data collection. We preferentially used the data of the right eye of the healthy controls in the analysis and exceptionally used the data of the left eye if the data of the right eye were inappropriate for analysis.
Each subject had a detailed ophthalmologic examination, including the assessment of refraction, best-corrected visual acuity reported as logarithm of the minimum angle of resolution (logMAR) values, colour vision, pupillary test, slit-lamp examination, tonometry, a fundus examination, and examination with a Humphrey visual field analyser using the 30-2 SITA-standard protocol (Humphrey 740 Visual Field Analyzer, Carl Zeiss Meditec, Inc. Dublin, CA, USA). Only reliable visual field results (33% or less false positives and false negatives; fixation losses of <20%) were used in the study. A worse visual field result was defined as a mean deviation (MD) value of −10 dB or less on the Humphrey visual field test [11].
OCT
All subjects underwent Spectralis OCT (Heidelberg Engineering, Heidelberg, Germany) with laser scanning of the optic nerve and macular regions within 2 months of symptom onset (acute stage) and at the follow-up visits. The images were acquired using automated eye alignment eye-tracking software (TruTrack; Heidelberg Engineering) for improving image quality and segmentation accuracy by compensating eye movements.
To describe the peripapillary scanning technique briefly, a 3.4 mm-diameter peripapillary circle scan centred on the optic disc was recorded and analysed for RNFL using the automated segmentation algorithm implemented in the proprietary software package version 5.1 from Heidelberg Engineering. The peripapillary RNFL was defined as the distance between the inner limiting membrane (ILM) and the GCL. The software divided the ring scan into four segments, which were 90° apart: the temporal RNFL, nasal RNFL, superior RNFL, and inferior RNFL.
In the macular area scan, 25 single horizontal axial scans were recorded and analysed, and only scans measured with high-quality (quality index > 20) were included in the study. Automated retinal segmentation was performed using Spectralis software to identify the individual retinal layers and quantify their thickness and total volume. The thickness of each layer between the ILM and Bruch’s membrane was measured automatically and divided into seven layers: the macular RNFL, GCL and IPL (GCIPL), inner nuclear layer (INL), outer plexiform layer (OPL), ONL, PRL, and the retinal pigment epithelium (RPE). The sum of those layers was calculated as the total retinal layer (TRL). For each layer, the SD-OCT automatically calculated the retinal thickness values for three concentric rings at 1 (central fovea), 3 (inner/parafoveal ring), and 6 mm (outer/perifoveal ring), dividing the inner and outer rings into 4 quadrants (nasal, superior, temporal, and inferior) and creating 9 total measurements per individual layer corresponding to the Early Treatment Diabetic Retinopathy Study areas [12]. All of the images were reviewed with respect to quality by neuro-ophthalmology experts. Due to errors associated with automated segmentation error as reported previously [13], we hand-corrected the data using manual segmentation.
Statistical analysis
The data are presented as the mean ± standard deviation. Linear time points reflecting serial microstructural changes were allocated to the best fit of the data: <2, 2–5 and 6–18 months for all layer thickness.
The mean retinal layer thicknesses of the healthy control eyes and NAION eyes at each time point were compared using an age-matched paired t-test. The rate of thickness change per month in each retinal layer was estimated using the generalised estimating equation (GEE) method after adjusting for age, gender and intra-subject inter-eye correlations, and the significance of the thickness change by months is indicated by p values. Bonferroni’s correction for multiple comparisons was applied to the p values by multiplying the uncorrected p values by 39 (for age-matched paired t-test) or 26 (for GEE analysis). A corrected p value of <0.05 was considered statistically significant. The association of changes in the OCT parameters with the final visual result was also analysed using logistic regression models with GEE. All statistical analyses were conducted using SPSS 25 software (IBM Corporation Software Group, Somers, NY, USA).
Results
Baseline clinical characteristics
Our retrospective study was comprised of 21 eyes of 17 patients with the first episode of NAION and 21 eyes of 21 healthy controls. The demographic data on all participants are summarised in Table 1. The mean age of the NAION patients was 63 ± 11 years (range, 40–83 years). The mean follow-up duration was 10 ± 4 months (range, 6–18 months). The mean initial logMAR visual acuity of the NAION eyes was 0.88 ± 0.94 (range, 0.00–3.00) and the final visual acuity of the NAION eyes was 0.72 ± 0.90 (range, 0.00–3.00). The mean MD of the NAION eyes at the final visual field examination was −14.22 ± 12.19 dB (range, 0.06 to −29.97 dB). Of the 21 eyes with NAION, 11 (52%) had worse visual field function with MD values of −10 dB or less at the final visits.
Longitudinal changes in retinal microstructure
Table 2 shows the mean peripapillary RNFL and macular retinal layer thicknesses of the NAION eyes and age-matched healthy control eyes at each time point. Table 3 shows the results of GEE estimates for the peripapillary RNFL and macular retinal layer thickness changes over time in the NAION eyes with adjustments for intra-subject inter-eye correlations, age, gender, and refractive errors. The peripapillary RNFL showed an increase in thickness in the acute stage within 2 months compared to the controls (p = 0.001). The peripapillary RNFL and macular RNFL measurements demonstrated significant reductions in thicknesses that occurred from the onset of symptoms to 2–5 months in the NAION eyes.
The magnitude of the reduction in the average peripapillary RNFL thickness was −19.8 µm/month (CI: −25.8 to −13.8 um/month, p < 0.001) and that of the macular RNFL was −14.5 µm/month (CI: −20.2 to −8.7 µm/month, p < 0.001). The magnitude of the reduction in peripapillary RNFL thickness between the onset and 2–5 months varied according to the sector. The superior sector demonstrated the most dramatic reduction in peripapillary RNFL thickness, with an estimated decrease in thickness of −27.9 µm/month (CI: −35.2 to −20.6 µm/month, p < 0.001). The temporal sector demonstrated the slowest rate of reduction in thickness at −12.4 µm/month (CI: −17.2 to −7.7 µm/month, p < 0.001).
After 2–5 months from the onset, the magnitude of the rate of thinning of the peripapillary RNFL decreased. The average peripapillary RNFL thinning rate after 2–5 months from the onset was −1.2 µm/month (CI: −2.1 to −0.2 µm/month, p = 0.494), which was not statistically significant, whereas the superior sector of the RNFL demonstrated significant thinning, with an estimated decrease in thickness of −1.4 µm/month (CI: −2.0 to −0.8 µm/month, p < 0.001) between 2–5 months and 6–18 months. After 2–5 months from the onset, the magnitude of the rate of macular RNFL thinning decreased to −1.5 µm/month (CI: −3.0 to 0.1 µm/month, p = 1.000) and the rate was not statistically significant.
There was no significant thinning of the GCIPL in the acute stage <2 months from onset (p = 0.183). However, the progressive thinning of the GCIPL started within 2–5 months from the onset and there appeared to be significant GCIPL thinning compared to the controls after 2–5 months from the onset (both p < 0.001). The rate of GCIPL thinning was greatest within 2–5 months from the onset at −26.8 µm/month (CI: −38.1 to −15.5 µm/month, p < 0.001) and the rate of thinning declined to −2.4 µm/month (CI: −4.2 to −0.5 µm/month, p = 0.286) between 2–5 and 6–18 months.
The ONL showed an increase in thickness compared to the controls in the acute stage within 2 months (p = 0.024). A reduction in the ONL thickness occurred after 2–5 months from the onset of symptoms at a rate of −2.6 µm/month (CI: −4.5 to −0.7 µm/month, p = 0.208) although the extent of the reduction did not reach statistical significance.
The INL, OPL, PRL and RPE were not significantly different from the controls at baseline, and there were no significant thickness changes over time.
Associations between final visual field results and retinal layer thickness and its temporal changes
To determine how each retinal layer and its thickness changes over time were associated with visual field outcomes, we used separate logistic regression analyses using GEE for the individual peripapillary and macular retinal layers with adjustments for intra-subject inter-eye correlation, age, gender and refractive errors. The patients were divided into two groups depending on the final visual field results. The patients in group1 had MD values greater than −10 dB and those in group 2 had MD values of −10 dB or less. The results of the association analysis between the OCT parameters at each time point and worse final visual field outcomes (MD values of −10 dB or less) are shown in Table 4.
At baseline, within 2 months from onset, no OCT parameters were significantly associated with the final visual field test results. At 2–5 months, the OCT parameters that were significantly associated with worse final visual fields were thinner temporal and superior peripapillary RNFLs (odds ratio (OR) = 0.94, p = 0.027 and OR = 0.91, p < 0.001, respectively). At 6–18 months, thinner peripapillary RNFLs in all sectors and thinner macular RNFL were significantly associated with worse visual field outcomes (average peripapillary RNFL OR = 0.79, p < 0.001; temporal peripapillary RNFL OR = 0.93, p = 0.018; nasal peripapillary RNFL OR = 0.94, p = 0.003; superior peripapillary RNFL OR = 0.91, p < 0.001; inferior peripapillary RNFL OR = 0.94, p < 0.001; and macular RNFL OR = 0.96, p = 0.018). There was no association between GCIPL, INL, OPL, ONL, PRL and RPE thickness at any time point and the visual field results.
The results of the association analysis between the estimated changes in each retinal layer thickness and visual field outcomes are shown in Fig. 1. Change in the peripapillary RNFL thickness over time showed significant associations with visual field outcomes (average peripapillary RNFL, p < 0.001; temporal peripapillary RNFL, p = 0.017; nasal peripapillary RNFL, p = 0.001; superior peripapillary RNFL, p < 0.001; inferior peripapillary RNFL, p = 0.002). From baseline to 2–5 months, more reduction in the thickness of the temporal peripapillary RNFL and superior peripapillary RNFL was associated with worse visual field results (OR = 0.94, p = 0.027 and OR = 0.91, p = 0.001, respectively). From baseline to 6–18 months, greater reduction rates in the peripapillary RNFL thickness of all sectors except the temporal sector were significantly associated with worse visual field outcomes (average peripapillary RNFL OR = 0.78, p < 0.001; nasal peripapillary RNFL OR = 0.94, p = 0.021; superior peripapillary RNFL OR = 0.91, p = 0.005; inferior peripapillary RNFL OR = 0.94, p = 0.003). The changes in GCIPL thickness over time were also significantly associated with final visual field results (p = 0.040). Greater decreases in the GCIPL thickness between baseline and 2–5 months were associated with worse visual field results (OR = 0.98, p = 0.036). Changes in the INL and ONL thickness over time also showed significant associations with visual field outcomes (p = 0.020 and p = 0.002, respectively). Less reduction in the thickness of the INL and ONL from baseline to 2–5 months was significantly associated with worse final visual outcomes in patients with MD values of ≤ −10 dB (OR = 1.02, p = 0.018, and OR = 1.01, p = 0.003, respectively). There was no association between the rate of change in the macular RNFL, OPL, PRL and RPE and visual field results.
To analyse the association between the estimated changes in each retinal layer thickness at each time point and visual field outcomes, we used separate generalised estimating equation analyses for individual peripapillary retinal nerve fibre layers and macular retinal layer thicknesses with adjustments for intra-subject inter-eye correlation, age, gender and refractive errors. A p value for the association between the overall estimated change in each retinal layer thickness and a worse visual field outcome is indicated. The estimated changes in retinal layer thickness at each time point significantly associated with worse final visual field are marked with an asterisk.
Discussion
Longitudinal changes in retinal microstructures
In this study, we investigated the longitudinal retinal layer changes in NAION patients. A significant thickening of the peripapillary RNFL and macular ONL was observed in patients with NAION in the acute phase at a mean of 22 days from the onset. After the acute phase, the peripapillary RNFL, macular RNFL and macular GCIPL were progressively reduced in thickness, and the peripapillary RNFL and macular RNFL, along with the GCIPL, became significantly thinner compared to those in healthy control eyes. Ackermann et al. previously reported the results of a cross-sectional study that showed a significant thickening in peripapillary retinal layers, including the peripapillary RNFL, in the acute phase of NAION [10]. In their study, no statistically significant alterations were found in the segmented macular layer thicknesses in acute NAION, but significant thinning of the macular RNFL, GCL and IPL and thickening of the ONL and external limiting membrane to Bruch’s membrane in particular regions were found in chronic NAION eyes compared to control eyes [10]. The discrepancy in the OCT results between studies could be related to the definition of the phases between the studies. The study by Ackermann et al. classified the acute phase as within 7 days from the onset and more than 6 weeks from the onset was classified as the chronic phase [10], whereas our study defined the acute phase as within 2 months from the onset and the chronic phase as more than 6 months from the onset.
In this study, the rate of thickness reduction in the peripapillary RNFL, macular RNFL and macular GCIPL was greatest from the onset of symptoms to 2–5 months. This finding may be partly related to the resolution of optic disc swelling after the acute onset of NAION, especially regarding the peripapillary RNFL thickness. The magnitude of the rate of decrease in the peripapillary RNFL thickness varied according to the sectors, with the greatest rate of decrease in the superior sector. The difference in the rate of thinning according to the sectors may be related to the fact that NAION usually affects the superior disc sectors more than the othe sectors [10]. It was previously suggested that more tightly packed axons and the correspondingly higher oxygen demand in the superior and inferior disc sectors relative to the nasal and temporal sectors allowed for a more rapid and severe onset of hypoxia in the former sectors [14]. Oedema of the optic disc often makes OCT analysis of the peripapillary RNFL not useful in evaluating or predicting the course of the disease in its initial stages [15] In this study, the peripapillary RNFL thickness was not significantly associated with the visual field outcomes in the acute phase. However, after the resolution of disc swelling, the peripapillary RNFL thickness became significantly associated with the final visual field outcomes. In addition, the rate of change in the peripapillary RNFL thickness within 2–5 months from the onset showed a significant association with visual field outcomes. The greater reduction in peripapillary RNFL thickness within 2–5 months from the onset, the worse the visual field.
Histopathological studies in rodent models of NAION indicated that an initial phase of GCIPL swelling on day 1 was followed by thinning of the GCIPL by weeks 2 and 4 [16]. This thinning was accompanied by a significant loss of retinal ganglion cell bodies. In this study, the GCIPL continued to reduce in thickness from the acute stage until 2–5 months. Swelling of the ischaemic axons that compress the capillaries located in the most superficial layers of the retina, aggravating tissue ischaemia in a vicious cycle, could explain this finding [2]. Keller et al. reported that GCIPL thickness correlated with the visual field at 1 month from the onset [9]. In our study, there was no significant association between the initial GCIPL thickness and the final visual field outcomes. Rather, the initial rate of GCIPL thinning was significantly associated with the visual field results. Worse visual field outcomes were observed when faster GCIPL thinning occurred after the acute phase.
Since the optic nerve is a part of the white-matter tract of the central nervous system, NAION is considered to be a white-matter stroke that occurs elsewhere in the brain [17].
NAION is presumed to result from circulatory insufficiency within the optic nerve head, but the specific location of the vasculopathy and its pathogenetic mechanism remains unproven [18]. Optic nerve ischaemia produces tissue oedema in the confined space of the optic nerve sheath [19]. This process results in a compartmental syndrome, with additional vascular compromise, similar to brain strokes that occur in the confined space of the skull [20]. As the cellular inflammatory response following infarction in the brain stroke was identified [21], studies revealed cellular inflammation in NAION in rodents, primate models and humans [19, 22]. In previous animal experiments, there was no electrophysiologic evidence of retinal dysfunction nor was there histological evidence of retinal damage other than thinning of the peripapillary RNFL [23]. Recently, one other study using OCT-angiography (OCT-A) reported microvascular changes in the superficial and deep layers of the retina in NAION [24]. In the OCT-A study, there was a decrease in vessel density in the deep capillary plexus below the inner border of the IPL closely related to the INL, in addition to an alteration of the superficial capillary plexus [24]. It was suggested that optic nerve head oedema, located within a rigid and narrow scleral canal, results in compression and slowing of the blood flow in the retinal vessels [24]. This vascular insult might result in reduced tissue perfusion in the corresponding retinal layer and lead to cytotoxic oedema. Unlike the inner retina, which is fed by a branch of the central retinal artery coming through the optic disc, the outer retina is supplied by the choroidal circulation and thus, it might be difficult to directly explain changes in the thickness resulting from hypoperfusion. In this study, the ONL showed an increase in thickness compared to the controls in the acute stage. After the acute stage, the ONL thickness started to decrease after 2–5 months and the mean ONL thickness at 6–18 months was not significantly different from that of the healthy controls. Oedema of the ONL lasting to 2–5 months was a predictor of worse visual outcome in this study. Ackermann et al. also reported ONL thickening in a few macular regions in NAION eyes compared to healthy control eyes in the chronic phases [10]. Keller et al. explained that swelling and damage to the nuclei in the photoreceptors in NAION eyes may play a key role in the pathogenic mechanism that leads to visual field deterioration [9]. They raised three hypotheses to explain the ONL thickening: the blood supply to the outer retina might be compromised, compartmental pressure caused by RNFL oedema could damage the photoreceptors, or the retina could maintain structural integrity by activating Müller cells [9], which are specialised glial cells that serve numerous functions, not only interacting actively with neurons and the vasculature in the central nervous system but also providing structural and metabolic support for neurons [25].
Our study had several limitations. First, this study was performed using the data of a single ethnic group. Thus, some results may not be valid in other ethnic groups. In addition, this study was retrospective in design. Although the follow-up schedule for the NAION patients was relatively uniform in our institute, there were some differences in follow-up intervals between a few patients. Third, a small number of subjects were included in the study.
Despite these deficiencies, we found significant structural changes in retinal layers following the onset of NAION. Significant thickening of the peripapillary RNFL and macular ONL were observed in the acute phase of patients with NAION. After the acute phase, the peripapillary RNFL, macular RNFL and macular GCIPL were progressively thinned. The initial rate of thickness changes in the peripapillary RNFL, GCIPL, INL and ONL by 2–5 months was a useful predictive factor of final visual field outcomes. In future studies, data including a larger number of NAION eyes and healthy individuals with longitudinal OCT data over time will be helpful in obtaining more information about structural changes in NAION over time and structure-function relationships.
Summary
What was known before
-
Peripapillary RNFL thickening on OCT was observed in the acute phase of NAION patients.
-
The thickness of the peripapillary RNFL was not useful for evaluating or predicting the course of NAION in the acute stage.
What this study adds
-
GCIPL thinning started within 2–5 months from the onset of NAION and the rate of thinning was faster than that after 2–5 months.
-
The rate of temporal and superior peripapillary RNFL and GCIPL thickness reduction within 2–5 months could predict the final visual outcomes.
-
Oedema of the ONL lasting to 2–5 months after onset could predict worse visual outcomes.
References
Hattenhauer MG, Leavitt JA, Hodge DO, Grill R, Gray DT. Incidence of nonarteritic anterior ischemic optic neuropathy. Am J Ophthalmol. 1997;123:103–7.
Hayreh SS. Ischemic optic neuropathy. Prog Retin Eye Res. 2009;28:34–62.
Levin LA, Louhab A. Apoptosis of retinal ganglion cells in anterior ischemic optic neuropathy. Arch Ophthalmol. 1996;114:488–91.
Aggarwal D, Tan O, Huang D, Sadun AA. Patterns of ganglion cell complex and nerve fiber layer loss in nonarteritic ischemic optic neuropathy by Fourier-domain optical coherence tomography. Investig Ophthalmol Vis Sci. 2012;53:4539–45.
Bellusci C, Savini G, Carbonelli M, Carelli V, Sadun AA, Barboni P. Retinal nerve fiber layer thickness in nonarteritic anterior ischemic optic neuropathy: OCT characterization of the acute and resolving phases. Graefes Arch Clin Exp Ophthalmol. 2008;246:641–7.
Tan O, Chopra V, Lu AT, Schuman JS, Ishikawa H, Wollstein G, et al. Detection of macular ganglion cell loss in glaucoma by Fourier-domain optical coherence tomography. Ophthalmology 2009;116:2305–14. e1-2.
Kernstock C, Beisse F, Wiethoff S, Mast A, Krapp E, Grund R, et al. Assessment of functional and morphometric endpoints in patients with non-arteritic anterior ischemic optic neuropathy (NAION). Graefes Arch Clin Exp Ophthalmol. 2014;252:515–21.
Cameron JR, Albrecht P, Cruz-Herranz A, Petzold A, Lagreze WA, Brandt AU. The APOSTEL recommendations for reporting quantitative optical coherence tomograph studies. Neurology 2016;87:1960.
Keller J, Oakley JD, Russakoff DB, Andorra-Ingles M, Villoslada P, Sanchez-Dalmau BF. Changes in macular layers in the early course of non-arteritic ischaemic optic neuropathy. Graefes Arch Clin Exp Ophthalmol. 2016;254:561–7.
Ackermann P, Brachert M, Albrecht P, Ringelstein M, Finis D, Geerling G, et al. Alterations of the outer retina in non-arteritic anterior ischaemic optic neuropathy detected using spectral-domain optical coherence tomography. Clin Exp Ophthalmol. 2017;45:496–508.
Danesh-Meyer HV, Papchenko T, Savino PJ, Law A, Evans J, Gamble GD. In vivo retinal nerve fiber layer thickness measured by optical coherence tomography predicts visual recovery after surgery for parachiasmal tumors. Investig Ophthalmol Vis Sci. 2008;49:1879–85.
Early Treatment Diabetic Retinopathy Study Research Group. Treatment techniques and clinical guidelines for photocoagulation of diabetic macular edema. Early Treatment Diabetic Retinopathy Study Report Number 2. Ophthalmology 1987;94:761–74.
Oberwahrenbrock T, Traber GL, Lukas S, Gabilondo I, Nolan R, Songster C, et al. Multicenter reliability of semiautomatic retinal layer segmentation using OCT. Neurol Neuroimmunol Neuroinflamm. 2018;5:e449.
Karam EZ, Hedges TR. Optical coherence tomography of the retinal nerve fibre layer in mild papilloedema and pseudopapilloedema. Br J Ophthalmol. 2005;89:294–8.
Kupersmith MJ, Anderson S, Durbin M, Kardon R. Scanning laser polarimetry, but not optical coherence tomography predicts permanent visual field loss in acute nonarteritic anterior ischemic optic neuropathy. Investig Ophthalmol Vis Sci. 2013;54:5514–9.
Ho JK, Stanford MP, Shariati MA, Dalal R, Liao YJ. Optical coherence tomography study of experimental anterior ischemic optic neuropathy and histologic confirmation. Investig Ophthalmol Vis Sci. 2013;54:5981–8.
Bernstein SL, Guo Y, Kelman SE, Flower RW, Johnson MA. Functional and cellular responses in a novel rodent model of anterior ischemic optic neuropathy. Investig Ophthalmol Vis Sci. 2003;44:4153–62.
Arnold AC. Pathogenesis of nonarteritic anterior ischemic optic neuropathy. J Neuroophthalmol. 2003;23:157–63.
Salgado C, Vilson F, Miller NR, Bernstein SL. Cellular inflammation in nonarteritic anterior ischemic optic neuropathy and its primate model. Arch Ophthalmol. 2011;129:1583–91.
Arnold AC. Anterior ischemic optic neuropathy. Semin Ophthalmol. 1995;10:221–33.
Gelderblom M, Leypoldt F, Steinbach K, Behrens D, Choe CU, Siler DA, et al. Temporal and spatial dynamics of cerebral immune cell accumulation in stroke. Stroke 2009;40:1849–57.
Zhang C, Guo Y, Miller NR, Bernstein SL. Optic nerve infarction and post-ischemic inflammation in the rodent model of anterior ischemic optic neuropathy (rAION). Brain Res. 2009;1264:67–75.
Chen CS, Johnson MA, Flower RA, Slater BJ, Miller NR, Bernstein SL. A primate model of nonarteritic anterior ischemic optic neuropathy. Investig Ophthalmol Vis Sci. 2008;49:2985–92.
Augstburger E, Zeboulon P, Keilani C, Baudouin C, Labbe A. Retinal and choroidal microvasculature in nonarteritic anterior ischemic optic neuropathy: an optical coherence tomography angiography study. Investig Ophthalmol Vis Sci. 2018;59:870–7.
Newman EA. Glial cell regulation of neuronal activity and blood flow in the retina by release of gliotransmitters. Philos Trans R Soc Lond B Biol Sci. 2015;370:20140195.
Funding
The authors received no specific funding for this work. This study followed tenets of the Declaration of Helsinki. The protocols used in this study were approved by the Institutional Review Board of Samsung Medical Center (2018-07-144).
Author information
Authors and Affiliations
Contributions
KAP and SYO made substantial contributions to the conception or design of the work. YL input the data into the spreadsheet, conducted the statistical analysis, wrote the initial draft of the paper and prepared the tables. KAP and SYO made contributions to interpreting the data, supervising the findings of the work, and revising and approving of the final paper.
Corresponding authors
Ethics declarations
Conflict of interest
The authors declare that they have no conflict of interest.
Additional information
Publisher’s note Springer Nature remains neutral with regard to jurisdictional claims in published maps and institutional affiliations.
Rights and permissions
About this article
Cite this article
Lee, Y., Park, KA. & Oh, S.Y. Changes in the structure of retinal layers over time in non-arteritic anterior ischaemic optic neuropathy. Eye 35, 1748–1757 (2021). https://doi.org/10.1038/s41433-020-01152-y
Received:
Revised:
Accepted:
Published:
Issue Date:
DOI: https://doi.org/10.1038/s41433-020-01152-y
- Springer Nature Limited